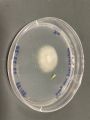

Endophyte Club
At the Endophyte Club biological hobbyists meet to identify, discover, discuss and trade information about new, rare and hard to access microorganisms. The race is on: who will get to unlock, collect and share the secrets of the microbiome era?
Members of the Endophyte Club will get hands-on experience setting up experiments and learning the DIY Biology methods needed to cultivate and isolate the microorganisms that live inside of plants (i.e. endophytes). We will also conduct field visits to collect plant samples and debate the use of endophytes as biopesticides as well as the ethical implications of biohacking for agriculture, the commercialization of science and the privatization of the commons. What other forms can our microbial future take?: A Lending library? An Internet of Plants? A Civilian Conservation Corps for Microbial Life?
Workshop Overview
During a 2 day lab participants learn how to collect agricultural plant samples (leaf, roots, etc.) and plate, grow, isolate and identify the microorganisms that grow inside the plants (Endophytes). The goal of the lab is to discover an entirely new organism and to take this DIY Bio research forward and to prototype its promise and limitations.
Applied endophyte research is being promoted as a possible replacement for chemical fertilizers and pesticides. In addition to learning basic biological lab techniques, we will be able to imagine different food futures and various registers and modes of biohacking.
Time table
FRIDAY, 2 December 2022 (10:00-16:00)
- 10:00 Canteen
- 16:00 Visit a supermarket
SATURDAY, 3 December 2022 (10:00-16:00)
- 10:00 Ilm park (tbc)
- 16:00 Lunch
Students
Literature
- Frank M. Dugan. (2017). Identification of Fungi.
- Jean Williams-Woodward, Simplified Fungi Identification Key, https://plantpath.caes.uga.edu/content/dam/caes-subsite/plant-pathology/extension-pdfs/PDL-fungi-key.pdf
- https://mycokeys.pensoft.net/article/23670/
- https://www.frontiersin.org/articles/10.3389/fmicb.2018.01707/full
- https://www.frontiersin.org/articles/10.3389/fbioe.2021.650351/full
- https://direct.mit.edu/books/oa-monograph/5330/chapter-standard/3809801/SymbioticA-Culturing-Art-and-Science
- http://critical-art.net/molecular-invasion-2002/
- https://monoskop.org/images/3/3a/Critical_Art_Ensemble_Digital_Resistance_Explorations_in_Tactical_Media.pdf
- https://mitpress.mit.edu/9780262514910/tactical-biopolitics/
Identification of endophytes
- Isolate and continue growing on a new plate
- Send it to sequence
- Repeat the experiment with the same plant a couple of times
- Isolate from different places the grown organism
- Do microscopy
Results
06 Dec 2022 -- miga
15 Dec 2022 -- Klaus
1. 2. und 3. Plating of surface sterilized Cranberry/Raspberry/Blueberry Samples
4. 5. 6. 7. Close ups:
„Japanische Aubergine“, produced in Spain, surface sterilized by 4 % Hypochlorid, Samples from inner fruit tissue and of surface/scin: